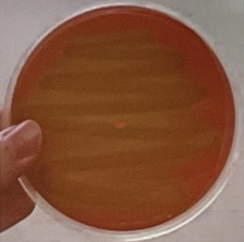
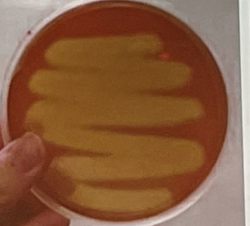
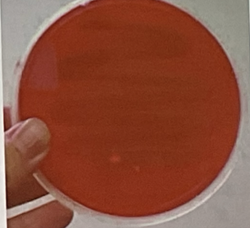
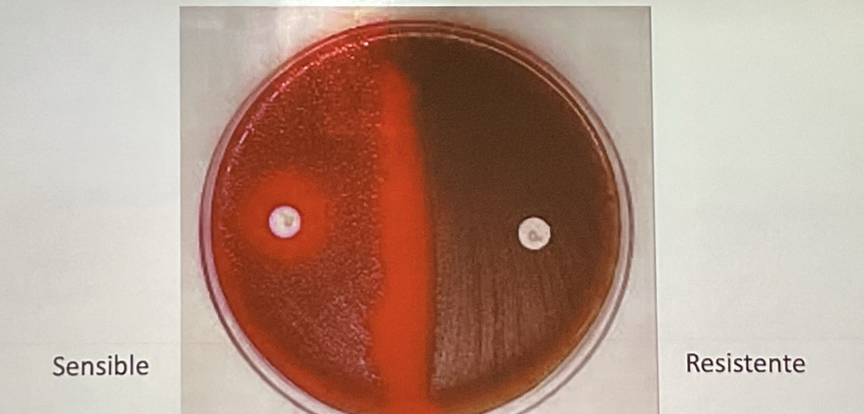
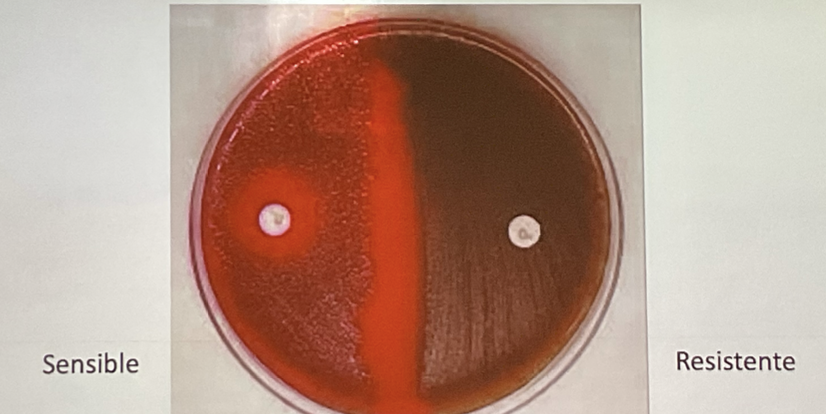

Cuáles son las 3 características microbiológicas de los STREPTOCOCCUS?
Cocos gram +, que se acomodan en pares (diplococos) o cadenas
Anaerobios facultativos
Catalasa negativa
Explica la ALPHA HEMOLISIS de los STREPTOCOCCUS
Eritrocitos de AGAR SANGRE alcanzan a destruirse pero no del todo, obtiene un color verdoso y transparente
Explica la BETA HEMOLISIS de los STREPTOCOCCUS
Es la hemolisis más compleja, ya que las bacterias alcanzan a destruir a los eritrocitos del AGAR SANGRE
Explica la GAMMA HEMOLISIS de los STREPTOCOCCUS
No hay hemolisis en el AGAR SANGRE
Que bacterias ESTREPTOCÓCICAS son sensibles a la OPTOQUININA y BACITRACINA?
Optoquinina: S. PNEUMONIAE
Bacitracina: S. PYOGENES
Que bacterias ESTREPTOCÓCICAS son resistentes a la OPTOQUININA y BACITRACINA?
Optoquinina: S. VIRIDANS
Bacitracina: S. AGALACTIAE
PX CON INFECCIÓN EN PARTE DEL CUERPO SALE CON MUESTRA Y EN MICROSCOPIO VES BACTERIAS GRAM+, CRECIO EN AGAR SANGRE Y HACE BETA HEMOLISIS, POR LO TANTO CUAL ES LA PRUEBA PARA SABER CUAL ES?
SENSIBILIDAD DE BACITRACINA PARA DIFERENCIAR ENTRE PYOGENES Y GALACTAE


